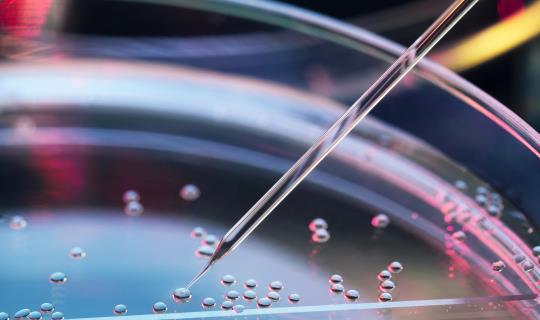
petri dish

Let's Ditch 2020 and Plan for 2021: Election What-Ifs
By AmerisourceBergen
Understandably, most of us cannot wait to turn the page to 2021. But to
do so, we must go through the first Tuesday in November—election day. In
a new issue brief,
Xcenda forecasts the health policy priorities for Congress and the next
Administration across the different election outcomes and compares the
presidential candidates’ viewpoints on drug pricing and insurance
coverage. Whatever the results from the upcoming election, we expect
healthcare to remain a key and immediate focus in Washington, DC, even
beyond COVID-19-related issues.
Topics:
Legislation
Managed care
Policy
Regulatory